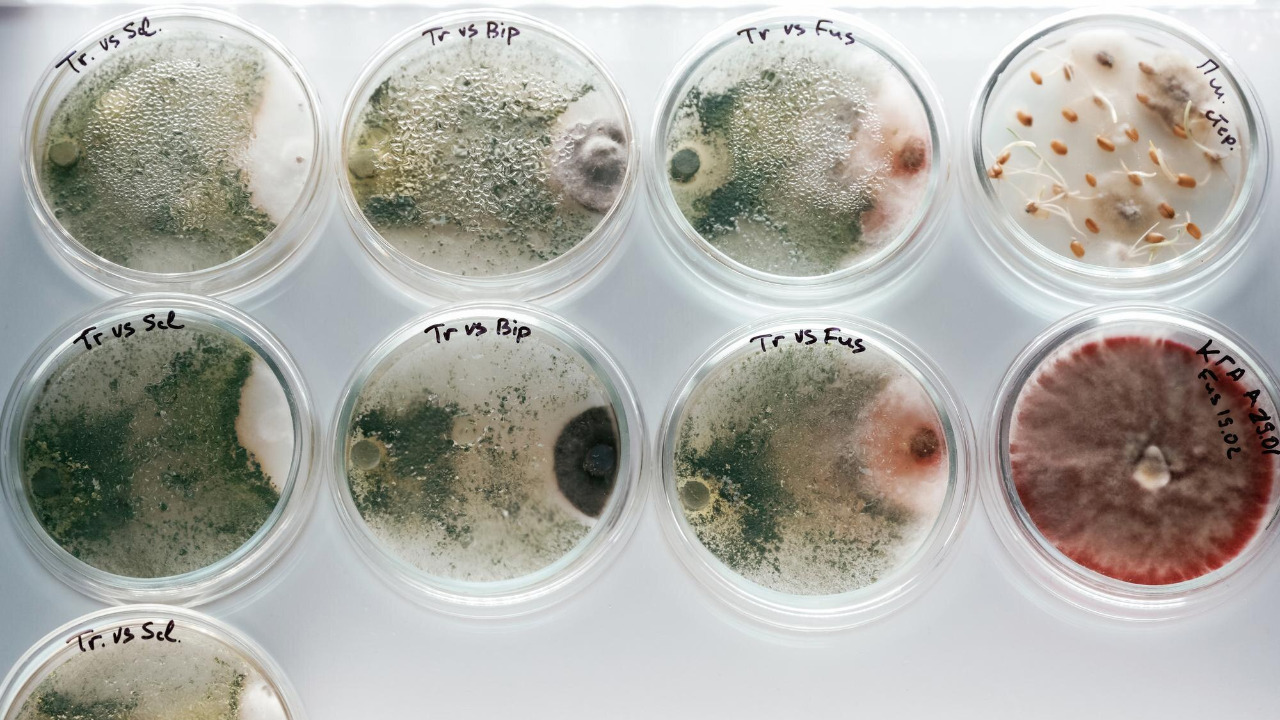
Image by Freepik

Recent discoveries have unveiled 214 ancient pathogens in prehistoric DNA, shedding light on early human interactions with infectious diseases. Among these pathogens is the earliest known strain of plague, providing valuable insights into the history of pandemics. This groundbreaking research offers a glimpse into how these ancient diseases might have shaped human evolution and societal development.
Unveiling Ancient Pathogens through DNA Analysis

Innovative Techniques in Paleogenomics
The field of paleogenomics has dramatically transformed our understanding of ancient diseases. By leveraging cutting-edge methodologies, scientists have been able to extract and analyze DNA from archaeological remains, some dating back thousands of years. Researchers use advanced sequencing technologies that allow them to identify genetic material from pathogens embedded in these ancient samples. These technologies have become increasingly sophisticated, enabling the detection of pathogens that were once thought to be irretrievable.
The use of high-throughput sequencing has been particularly instrumental in this research. This method allows for the simultaneous sequencing of millions of DNA fragments, providing a comprehensive view of the genetic material present in a sample. By applying these techniques, scientists have been able to reconstruct genomes of ancient pathogens, offering unprecedented insights into their diversity and evolution over time.
Significant Discoveries and Milestones
The analysis of ancient DNA samples has led to several key findings, reshaping our understanding of ancient human health. One of the most significant discoveries is the identification of 214 different pathogens, including bacteria and viruses. These findings suggest that ancient humans were exposed to a wide variety of infectious diseases, some of which may have played a crucial role in shaping human evolution and societal development.
The implications of these discoveries are far-reaching. By understanding the types of pathogens that affected ancient populations, researchers can gain insights into how these diseases influenced migration patterns, population dynamics, and even the development of human immunity. For instance, the presence of certain pathogens in specific regions may indicate historical trade routes or migration patterns, providing a clearer picture of how ancient societies interacted and evolved.
The Earliest Known Strain of Plague

Tracing the Origins of Plague
Among the pathogens identified in prehistoric DNA is the earliest known strain of plague. This discovery has significant implications for our understanding of the history of pandemics. The strain, found in a sample dating back over 5,000 years, predates previously known examples of plague by several millennia. This finding challenges existing theories about the origins of this devastating disease, suggesting that it may have emerged much earlier than previously thought.
The identification of this early plague strain provides new insights into the evolutionary history of the pathogen. By comparing the genetic material of this ancient strain with those from later outbreaks, scientists can trace the changes in the pathogen over time. This information is crucial for understanding how the plague evolved to become one of history’s deadliest diseases, responsible for multiple pandemics throughout human history.
Impact on Human Populations
The discovery of the earliest known plague strain has important implications for our understanding of its impact on prehistoric communities. The presence of this pathogen in ancient DNA samples suggests that early human populations may have been more affected by infectious diseases than previously believed. This could have had profound effects on their social structures, economies, and even their genetic makeup.
By examining how the early plague affected prehistoric communities, researchers can draw comparisons with later, more documented outbreaks, such as the Black Death. Understanding how ancient populations responded to and survived these early pandemics can provide valuable lessons for contemporary public health strategies. Moreover, these findings highlight the resilience of human populations in the face of devastating diseases, offering a testament to the adaptability and ingenuity of our ancestors.
Pathogen Transmission from Animals to Humans
Zoonotic Disease Origins
A critical aspect of this research is the evidence supporting the transmission of diseases from animals to humans, known as zoonotic diseases. The study of prehistoric DNA has revealed that such transmissions occurred as far back as 6,500 years ago. This finding is supported by analyses of animal remains found in close proximity to human settlements, suggesting a link between domesticated animals and the spread of ancient pathogens.
Domesticated animals likely played a significant role in the transmission of zoonotic diseases. As humans began to live in closer quarters with animals, the likelihood of disease transmission increased. Evidence from archaeological sites indicates that animals such as cattle and pigs were common sources of zoonotic diseases, contributing to the spread of pathogens among human populations.
Human Adaptation and Evolution
The exposure to zoonotic diseases had a profound impact on human evolution, particularly in terms of immune system development. Early humans who survived these diseases likely possessed genetic traits that conferred resistance, which were then passed on to subsequent generations. This process of natural selection played a key role in shaping the human immune system, enabling it to better respond to a wide range of pathogens.
Furthermore, the survival strategies developed by prehistoric humans in response to these diseases highlight their adaptability and resourcefulness. By studying ancient DNA, researchers can gain insights into how early humans adapted to their environments, developing new tools and practices to mitigate the effects of infectious diseases. These strategies may have included changes in settlement patterns, dietary practices, and social structures, all of which contributed to the resilience of ancient populations.
Implications for Modern Science and Medicine

Lessons for Contemporary Pandemic Preparedness
The study of ancient pathogens provides valuable lessons for contemporary pandemic preparedness. By understanding how past societies were affected by infectious diseases, we can develop more effective public health strategies to address current and future pandemics. The insights gained from ancient DNA research can inform the development of surveillance systems, vaccination programs, and other interventions that aim to reduce the impact of pandemics on modern populations.
In addition, the study of ancient pathogens can help predict future pandemic trends. By analyzing patterns of disease emergence and spread in the past, researchers can identify potential risk factors and develop strategies to mitigate their impact. This approach can help ensure that societies are better equipped to respond to pandemics, minimizing their effects on health and well-being.
Advancing Understanding of Pathogen Evolution
The study of ancient pathogens contributes significantly to the broader field of evolutionary biology. By examining how pathogens have evolved over time, researchers can gain insights into the mechanisms that drive their adaptation and survival. This knowledge is crucial for developing new medical treatments and interventions, as it provides a foundation for understanding how pathogens may respond to different therapeutic approaches.
Moreover, ancient DNA research can inform the development of new vaccines and treatments. By identifying the genetic characteristics of ancient pathogens, scientists can design interventions that target specific vulnerabilities in their genomes. This approach has the potential to revolutionize the development of treatments for infectious diseases, offering new hope for combating some of the world’s most challenging health threats.
